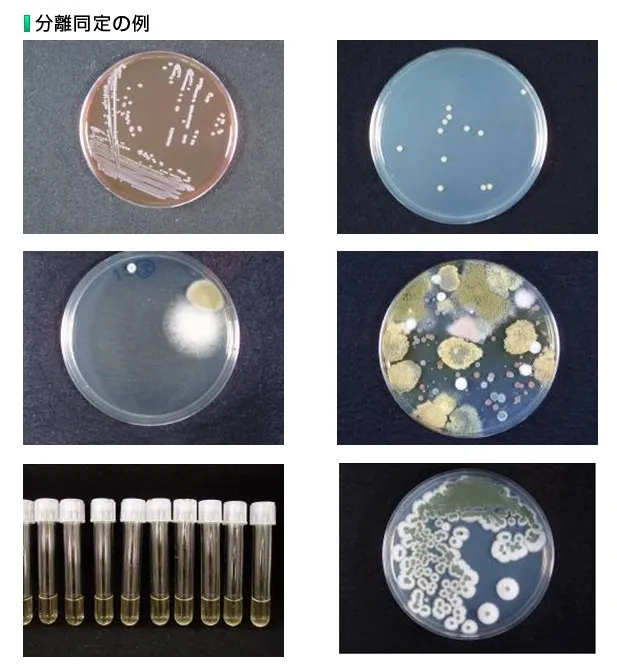

家庭に潜む黒色真菌「Exophiala(エクソフィアラ)」とは?食洗機・加湿器に潜むカビの正体と健康リスクを徹底解説|東北のカビ相談はカビバスターズ仙台へ
2026/01/14
家庭に潜む黒色真菌「Exophiala(エクソフィアラ)」とは?食洗機・加湿器に潜むカビの正体と健康リスクを徹底解説|東北のカビ相談はカビバスターズ仙台へ
見えない場所で静かに増える危険なカビ…皮膚や肺への影響も?真菌検査で原因を見える化し、再発しない住環境へ
こんにちは😊
東北地方のカビトラブル解決を専門に行っている MIST工法®カビバスターズ仙台 です!
「しっかり掃除しているのに、なぜかカビ臭い…💦」
「加湿器や食洗機を使うと、黒い汚れが気になる…😢」
そんなお悩みをお持ちではありませんか?
実はその正体、Exophiala(エクソフィアラ) という“黒色真菌”かもしれません。
エクソフィアラは湿気・温度・水分を好み、家庭用の食洗機・加湿器・浴室周辺など、人の目が届きにくい場所に静かに定着します。見た目は地味でも、稀に皮膚や肺へ影響を及ぼすことがあり、決して軽視できないカビ菌です⚠️
現代の住宅は高気密・高断熱化が進み、一度カビが発生すると再発しやすい構造になっています。だからこそ、「除去」だけでなく、**なぜ発生したのか?原因はどこにあるのか?**をしっかり調査することがとても重要なのです。
私たちカビバスターズ仙台では、
✔ 壁の中を確認するファイバースコープ調査
✔ 室内建材の含水率検査
✔ 風量計による負圧チェック
などを行い、カビ発生の根本原因を徹底的に追究します🔍
また、一般社団法人微生物対策協会と連携した真菌(カビ菌)検査により、「何のカビが、どこに、どのくらい存在しているのか」を見える化することも可能です✨
カビ問題が少しでも心配な方には、まずこの真菌検査を強くおすすめしています。
「これは自分で対処できるのかな…?」
「もう何度も再発していて不安…」
そんな手に負えないカビトラブルは、ぜひ一度 MIST工法®カビバスターズ仙台 にご相談ください😊
東北の住まいと健康を守るため、私たちは全力でサポートいたします🌈
目次
Exophiala(エクソフィアラ)とは?黒色真菌と呼ばれるカビの正体
家庭の中にひっそり潜む“黒いカビ菌”|見た目では判断しにくいExophialaの特徴をわかりやすく解説
Exophiala(エクソフィアラ)とは、**「黒色真菌(こくしょくしんきん)」**と呼ばれるカビの一種です。
名前を聞いてもピンとこない方がほとんどだと思いますが、実はこのカビ、私たちの身近な生活空間にひっそりと存在している可能性がある、少し厄介な存在なのです😣💦
エクソフィアラの大きな特徴は、黒っぽい色をしており、湿気と水分を非常に好むという点です。特に、温度と湿度が安定しやすい環境では増えやすく、家庭内では目に見えない場所に定着することが多いため、気づかないうちに広がってしまうケースも少なくありません。
一般的なカビは、壁や天井、浴室のタイル目地など「目に見える場所」に発生することが多いですが、エクソフィアラは
・食洗機の内部
・加湿器の水がたまる部分
・配管や排水まわり
など、普段の掃除ではなかなか手が届かない場所を好みます🚿
さらに厄介なのは、
「黒ずんでいるけど、汚れなのかカビなのかわからない」
「掃除しても、しばらくするとまた黒くなる」
といったように、見た目だけでは判断が難しい点です。
エクソフィアラは、通常はすぐに健康被害を引き起こすカビではありませんが、稀に皮膚や肺に影響を及ぼすことがあるとされており、特に小さなお子さまや高齢の方、免疫力が低下している方がいるご家庭では注意が必要です⚠️
「ただの汚れだと思っていたものが、実はカビだった…」
そんなケースも決して珍しくありません。
だからこそ、カビ問題では
✔ 何のカビなのか
✔ どこに、どのくらい存在しているのか
を正しく知ることが、とても大切なのです。
次の章では、なぜエクソフィアラが家庭内で増えやすいのか、その環境条件について詳しく解説していきます😊
なぜ家庭内で増えるの?エクソフィアラが好む環境とは
湿気・水分・見えない空間が大好物!現代住宅でエクソフィアラが増えやすい理由
「どうしてこんな場所にカビが?」
そう感じたことはありませんか?🤔
エクソフィアラが家庭内で増えやすい理由は、現代の住まい環境そのものに深く関係しています。
まず知っておいていただきたいのが、現在の住宅は
高気密・高断熱でとても快適に作られている、という点です🏠✨
しかしこの構造、実はカビにとってはとても住みやすい環境になりやすいのです。
🌧️エクソフィアラが好む3つの条件
エクソフィアラは、特に次のような環境を好みます。
1️⃣ 湿気が多い場所
2️⃣ 水分が常に存在する場所
3️⃣ 空気の流れが悪く、見えない場所
例えば、
・結露が起きやすい室内
・換気が不十分な水回り
・壁の中や床下などの密閉空間
こうした場所は、人にとっては気づきにくくても、カビにとっては絶好の繁殖環境なのです😨
💧「水」がある限り、カビは生き続ける
エクソフィアラは、ほんのわずかな水分でも生き延びる力を持っています。
加湿器の内部に残った水、食洗機の見えない内部の湿気、配管まわりの結露…。
これらはすべて、エクソフィアラが定着しやすい条件に当てはまります。
「毎日使っているから大丈夫」
「定期的に掃除しているから問題ない」
そう思っていても、内部に残った湿気や水分までは完全に取り切れないことが多く、気づかないうちにカビが根を張ってしまうケースも少なくありません。
🏠 建物の中が“ブラックボックス”になっている
さらに厄介なのが、
壁の中・天井裏・床下など、目で確認できない場所です。
こうした場所では、
・建材に水分が含まれている
・通気が悪い
・結露が慢性的に発生している
といった状況が重なりやすく、知らない間にカビが増殖していることもあります。
実際に、
「表面はきれいなのに、なぜかカビ臭い…」
というご相談の多くは、見えない内部環境に原因があるケースです。
⚠️原因を放置すると再発のリスクが高い
エクソフィアラに限らず、カビは
発生した原因を改善しない限り、何度でも再発する可能性があります。
現代の住宅では特に、
✔ 湿気
✔ 水分
✔ 空気の流れ
この3つのバランスが崩れると、カビが定着しやすくなります。
そのため、
「とりあえず掃除する」
「見える部分だけきれいにする」
だけでは、根本的な解決にはならないことが多いのです💦
次の章では、
**「特に注意すべき場所」**として
👉 食洗機・加湿器など、エクソフィアラが潜みやすい具体的な場所
を詳しくご紹介していきます😊
食洗機・加湿器に要注意!エクソフィアラが潜みやすい場所
毎日使っているからこそ危険?見落としがちな家電・設備の中で増える黒色真菌
「まさか、家電の中にカビがいるなんて…😳」
そう思われる方も多いかもしれませんが、エクソフィアラは“家電の内部”を非常に好むカビです。
特に注意したいのが、水と湿気を使う家電や設備。
普段は見えない場所だからこそ、知らないうちにカビが定着してしまうことがあります。
🍽️ 食洗機の内部はカビにとって理想的な環境
食洗機は
✔ 水を使う
✔ 温度が一定
✔ 使用後もしばらく湿気が残る
という特徴があり、エクソフィアラにとってはとても快適な空間です。
庫内はきれいに見えても、
・フィルターの奥
・排水まわり
・ゴムパッキンの裏側
などは、普段の掃除ではなかなか確認できません💦
そこにわずかでも水分が残ると、黒っぽいカビが少しずつ増えていくことがあります。
🌫️ 加湿器の内部は要注意ポイント
加湿器も、エクソフィアラが好む代表的な場所です。
特に
・タンク内部
・給水部分
・吹き出し口の奥
は、水が常に存在する状態になりやすく、管理が不十分だとカビが繁殖しやすくなります。
「毎日水を替えているから大丈夫」
と思っていても、内部の細かな部品や見えない部分までは完全に乾かせないことが多く、知らない間にカビが残ってしまうケースもあります😥
🚿 配管・排水まわり・水回り設備
そのほかにも、
・洗面台やキッチンの排水まわり
・浴室の裏側
・洗濯機の内部やホース
なども、エクソフィアラが潜みやすい場所です。
これらの共通点は、
👉 湿気が多い
👉 水が完全に乾きにくい
👉 空気がこもりやすい
という点。
見えない=安全、ではないのがカビの怖いところです⚠️
😟「掃除しているのに再発する」理由
「きちんと掃除しているのに、また黒ずみが出てくる…」
という場合、表面だけでなく内部に原因が残っている可能性があります。
カビは、
✔ 見える部分だけ除去しても
✔ 原因となる湿気・水分・環境が残っていると
何度でも再発してしまいます。
特にエクソフィアラは、人の目が届かない場所で静かに増えるタイプのカビ。
そのため、「気づいたときには広がっていた」というご相談も少なくありません。
🔍 気になる場合は“調べること”が第一歩
「うちの食洗機、大丈夫かな?」
「加湿器、もしかして…?」
そんな不安を感じたら、自己判断せずに調査・検査を行うことが大切です。
カビは種類によって性質が異なるため、正体を知ることが再発防止への近道になります😊
次の章では、
👉 エクソフィアラが健康に与える影響
について、必要以上に怖がらせず、わかりやすく解説していきます。
見た目以上に怖い?エクソフィアラが健康へ与える影響
「ただの黒い汚れ」と思っていませんか?体調不良との意外な関係をやさしく解説
エクソフィアラは、一般的なカビと比べると
「すぐに強い症状が出る」
というタイプではありません。
そのため、
「見た目がちょっと黒いだけ」
「掃除すれば大丈夫そう」
と、軽く考えられてしまうことが多いカビでもあります😌
しかし、実はそこに落とし穴があるのです。
🦠 エクソフィアラは“静かに影響する”カビ
エクソフィアラは、黒色真菌と呼ばれる仲間で、
長期間にわたって室内に存在すると、少しずつ体へ影響を及ぼす可能性があります。
報告されている影響としては、
・皮膚への感染(まれ)
・肺への影響(非常にまれ)
などがありますが、特に注意したいのは、日常的な体調不良との関係です。
😷 こんな症状、思い当たりませんか?
次のような症状が、
「原因がよくわからないまま続いている」
という場合、室内環境が関係している可能性もあります。
✔ 咳や喉の違和感が長引く
✔ 朝起きると鼻がムズムズする
✔ 室内にいると、なんとなく体が重い
✔ カビ臭い空気が気になる
もちろん、すべてがカビ原因とは限りません。
ですが、カビの種類や量によっては、空気環境に影響を与えることがあるのは事実です。
👶 高齢者・お子さまがいるご家庭は特に注意
エクソフィアラに限らず、カビは
・小さなお子さま
・ご高齢の方
・体調を崩しやすい方
がいるご家庭では、より慎重に考える必要があります。
「今は大丈夫そうだから…」
と放置してしまうと、知らないうちに室内環境が悪化していることも😥
🏠 目に見えない場所のカビが影響することも
カビの怖いところは、
目に見える量よりも、“どこに・どんな種類が存在しているか”が重要
という点です。
例えば、
・壁の中
・天井裏
・床下
といった場所にカビがあると、空気の流れによって室内に影響が及ぶこともあります。
「見えるところはきれいなのに、体調がすぐれない」
そんな場合こそ、目に見えない部分の確認が重要になります🔍
🔬 健康を守るために“真菌検査”という選択
カビ問題で大切なのは、
👉 むやみに怖がらないこと
👉 正しく知ること
その第一歩が、真菌(カビ菌)検査です。
どんなカビが、
どこに、
どのくらい存在しているのか
を把握することで、不要な不安を減らし、適切な判断ができるようになります😊
次の章では、
👉 なぜ表面の掃除だけでは再発してしまうのか
👉 現代住宅とカビの深い関係
について、さらにわかりやすく解説していきます✨
表面だけ掃除しても再発する理由|現代住宅とカビの関係
「きれいにしたはずなのに、またカビ…」その原因は“見えないところ”にあります
「市販の洗剤で掃除したのに、しばらくするとまた黒くなる…😥」
カビのご相談で、とても多いお悩みです。
実はこれ、掃除の仕方が悪いわけでも、手抜きでもありません。
原因は“現代の住宅構造”と“カビの性質”にあります。
🏠 現代の住宅はカビが潜みやすい?
現在の住宅は、
✔ 高気密
✔ 高断熱
✔ 省エネ設計
とても快適に作られています✨
しかしその一方で、湿気や水分が逃げにくい構造にもなっています。
その結果、
・結露が発生しやすい
・壁の中に湿気がこもる
・空気の流れが悪くなる
といった状態が起きやすく、カビにとっては住みやすい環境ができてしまうのです😣
🧽 表面のカビ=氷山の一角
目に見えるカビを掃除すると、
「これで解決した!」
と感じますよね😊
ですが、カビは
👉 表面に見えている部分
👉 見えない内部(壁の中・建材・裏側)
両方に存在していることが多いのです。
表面だけをきれいにしても、
・壁の中
・建材の内部
・湿気が残る場所
に原因が残っていれば、時間の問題で再発してしまいます。
💧 建材に含まれた「水分」がカビを育てる
実は、カビは
建材に含まれた水分(含水率)
を栄養にして増えることがあります。
見た目が乾いていても、
・壁材
・木材
・断熱材
の内部に水分が残っていると、カビは活動を続けます。
「雨漏りはしていないから大丈夫」
と思っていても、
✔ 結露
✔ 配管まわりの湿気
✔ 生活による水蒸気
などが原因で、知らないうちに水分がたまっているケースも少なくありません。
🌬️ 空気の流れも再発のカギ
もうひとつ重要なのが、空気の流れです。
室内が
・負圧になっている
・換気がうまく機能していない
と、湿気やカビの影響が室内全体に広がりやすくなります。
そのため、
「一部だけカビが出ている」
と思っていても、家全体の環境が影響していることもあるのです⚠️
🔁 原因改善をしない限り、再発リスクは高い
カビ問題で最も大切なのは、
👉 なぜ発生したのか?
👉 どこに原因があるのか?
を明確にすることです。
掃除や拭き取りは「対処」であって、
原因改善ではありません。
だからこそ、
・見えない場所の確認
・水分量のチェック
・空気環境の確認
といった調査を行うことが、再発防止の第一歩になります😊
次の章では、
👉 カビ問題はなぜ「原因調査」が重要なのか
👉 再発を防ぐために欠かせない考え方
を、さらに具体的に解説していきます✨
カビ問題は「原因調査」が重要!再発を防ぐために必要な視点
見えない原因を見逃さないことがカギ|その場しのぎではカビは止まらない理由
カビのお悩みでとても多いのが、
「一度きれいにしたのに、また同じ場所にカビが出た…😢」
という声です。
このようなケースで共通しているのが、
カビが発生した“原因そのもの”が分からないまま対処している
という点です。
🔍 カビは「結果」、原因は別にある
実は、目に見えるカビは
👉 問題の結果として現れているサイン
にすぎません。
本当の原因は、
・湿気がたまりやすい構造
・建材に残った水分
・空気の流れの乱れ
・壁の中や天井裏の環境
など、目では確認できない場所にあることがほとんどです。
そのため、
「黒いところを掃除する」
「カビ臭い場所だけ対処する」
だけでは、根本的な解決にはならないのです💦
🏠 現代住宅は“調査しないと分からない”
今の住宅は、見た目はとてもきれいで快適です✨
しかしその分、
✔ 壁の中
✔ 床下
✔ 天井裏
といった場所は、簡単には確認できない構造になっています。
「表面に異常がないから大丈夫」
と思っていても、
内部では湿気がこもり、カビが静かに広がっている
というケースも実際にあります😨
📏 水分・空気・内部状態を確認する重要性
カビの再発を防ぐためには、
次のようなポイントを客観的に確認することがとても重要です。
✔ 建材にどれくらい水分が含まれているのか
✔ 壁の中や見えない部分はどんな状態なのか
✔ 室内の空気の流れは正常か
これらを調べずに判断してしまうと、
「原因が残ったまま」になり、再発リスクが高い状態が続いてしまいます。
🌬️ 空気環境の乱れがカビを広げることも
室内が負圧の状態になっていると、
壁の隙間や建物内部から、
湿気やカビの影響が室内へ引き込まれることがあります。
つまり、
「一か所の問題」だと思っていたカビが、
家全体の環境に関係していることもあるのです。
🔁 原因調査は“遠回りのようで一番の近道”
原因調査というと、
「大げさそう…」
「そこまで必要?」
と感じる方もいらっしゃるかもしれません😊
ですが実際には、
✔ 何度も掃除を繰り返す
✔ 不安を抱えたまま生活する
✔ 同じトラブルが何度も起きる
こうした状況を防ぐための、一番の近道が原因調査です。
🌱 不安を減らすためにも“知ること”が大切
カビ問題は、
「分からない」ことが一番のストレスになります。
だからこそ、
👉 今の住まいがどんな状態なのか
👉 何が原因でカビが出ているのか
を知ることで、不要な不安を減らし、正しい判断ができるようになります😊
次の章では、
👉 真菌検査でカビを「見える化」する重要性
👉 微生物対策協会と連携した検査のメリット
について、さらに詳しく解説していきます🔬✨
真菌検査でカビを見える化|正しい対策のために欠かせない理由
「何のカビかわからない」が一番危険?目に見えない不安を“安心”に変える第一歩
カビのご相談を受けていると、
「これって、どんなカビなんでしょうか…?」
というご質問をとても多くいただきます🤔
実は、**カビ対策でいちばん避けたいのが“正体が分からないまま対処すること”**です。
🦠 カビは種類によって性質がまったく違う
一口に「カビ」と言っても、
✔ 増えやすさ
✔ 好む環境
✔ 体への影響
✔ 再発しやすさ
は、種類によって大きく異なります。
見た目が黒いからといって、
すべて同じカビとは限りません😣
Exophiala(エクソフィアラ)のように、
家庭内の水回りや内部環境に定着しやすい黒色真菌も存在します。
だからこそ、
👉 何のカビなのかを知ること
がとても重要なのです。
🔬 真菌検査で「見えない情報」を見える化
真菌検査では、
・室内の空気
・表面の付着物
・疑わしい場所
などからサンプルを採取し、
どんなカビ菌が存在しているのかを客観的に確認します。
これにより、
✔ ただの汚れなのか
✔ 放置してよいレベルなのか
✔ 注意が必要なカビなのか
を、感覚ではなく“データ”で判断できるようになります😊
🌱 不要な不安を減らすための検査
「検査」と聞くと、
「大げさそう…」
「怖い結果が出そう…」
と感じる方もいらっしゃるかもしれません。
ですが実際には、
何も問題がないと分かって安心するケースも多くあります✨
逆に、
「知らないまま生活し続ける」
ことのほうが、ストレスや不安につながってしまうことも😥
🏠 見えない場所のカビこそ検査が重要
カビは、
・壁の中
・天井裏
・床下
など、目に見えない場所に潜んでいることが多いため、
見た目だけで判断するのはとても危険です⚠️
真菌検査を行うことで、
「今の住環境がどんな状態なのか」
を把握でき、今後どうすればよいかの判断材料になります。
🤝 専門機関と連携した検査で安心感を
真菌検査は、
✔ 正確さ
✔ 客観性
✔ 信頼性
がとても重要です。
専門機関と連携した検査を行うことで、
思い込みや自己判断ではない、根拠のある対応が可能になります。
🌼 カビが心配な方へ|まずは“知ること”から
「今すぐ何かしないといけないの?」
「様子を見ても大丈夫?」
そんな判断に迷ったときこそ、
真菌検査は心強い味方になります😊
次の章では、
👉 建物内部をどうやって確認するのか?
👉 壁の中・水分・空気の状態を調べる調査方法
について、さらにわかりやすく解説していきます🔍✨
建物内部も見逃さない!壁の中・水分・空気の状態を確認する調査
見えないからこそ要注意|カビの本当の原因は“建物の中”に隠れていることがあります
「壁の中まで調べる必要があるんですか?」
これは、カビ相談の現場でとてもよくいただく質問です😊
結論からお伝えすると、
再発を防ぎたいのであれば、建物内部の確認はとても重要です。
なぜなら、カビは
👉 目に見える場所よりも
👉 見えない場所で静かに増えていることが多い
からです。
🔍 壁の中は“ブラックボックス”
普段の生活では、
・壁の中
・天井裏
・床下
を目で確認することはできませんよね。
しかし、カビの原因はこうした見えない空間に潜んでいるケースが非常に多いのです😨
例えば、
✔ 壁内で結露が起きている
✔ 配管まわりに湿気がたまっている
✔ 断熱材が湿っている
といった状態は、外から見ただけでは分かりません。
📷 ファイバースコープで内部の状態を確認
建物内部の確認には、
**細いカメラ(ファイバースコープ)**を使うことで、
壁の中や普段見えない場所の状態を直接確認することができます🔍✨
これにより、
・カビの有無
・水染み
・結露の形跡
などを、目で見て判断できるようになります。
「見て分かる」というのは、
不安を減らすうえでも、とても大きなポイントです😊
📏 建材の「含水率」を測る理由
カビの発生と深く関係しているのが、
**建材に含まれている水分量(含水率)**です。
見た目が乾いていても、
建材の内部に水分が残っていると、
カビは活動を続けることができます。
含水率を測定することで、
✔ 乾いているつもりの場所が本当に乾いているのか
✔ カビが育ちやすい状態なのか
を、数値で判断できるようになります📊
🌬️ 空気の流れと負圧も重要なチェックポイント
もうひとつ見逃せないのが、室内の空気の流れです。
建物が
・負圧の状態
・換気がうまく機能していない
場合、
壁の中や床下から、
湿気やカビの影響が室内に引き込まれてしまうことがあります⚠️
風量計などを使って空気の状態を確認することで、
「なぜカビ臭さが取れないのか」
「なぜ特定の部屋だけ調子が悪いのか」
といった疑問のヒントが見えてくることもあります。
🔁 調査は“カビ対策の土台”
カビ対策というと、
「目に見えるカビをどうするか」
に意識が向きがちですが、実はそれはほんの一部です。
✔ 建物内部の状態
✔ 水分の有無
✔ 空気環境
これらを確認してこそ、
再発しにくい環境づくりのスタートラインに立てます😊
🌱 「何もなければ安心」という結果も大切
調査を行った結果、
「大きな問題はありませんでした」
というケースもあります✨
それは決して無駄ではなく、
安心して暮らすための大切な情報です。
次の章では、
👉 「これってカビ?」と感じたときのチェックポイント
👉 相談すべきタイミング
を、具体的にご紹介していきます😊
こんな症状があったら要注意!カビトラブルのチェックポイント
「まだ大丈夫」と思っていませんか?見逃されやすいカビのサインをセルフチェック
カビのトラブルは、
はっきり目に見える前にサインを出している
ことがとても多いです👀
しかしそのサインは、
「気のせいかな?」
「一時的なものだろう」
と見過ごされてしまいがち😥
ここでは、カビ問題を疑ったほうがよいチェックポイントを、わかりやすくご紹介します。
✅ チェック① カビ臭・湿っぽいニオイがする
部屋に入った瞬間、
・ジメッとしたニオイ
・土っぽい、カビっぽいニオイ
を感じることはありませんか?
これは、目に見えない場所でカビが発生しているサインのひとつです。
特に
・クローゼット
・押し入れ
・洗面所や脱衣所
で感じる場合は注意が必要です⚠️
✅ チェック② 窓・壁・家具まわりの結露が多い
結露は、
**カビが育つための「水分供給源」**になります💧
✔ 窓のまわりがいつも濡れている
✔ 壁紙がしっとりしている
✔ 家具の裏が湿っている
こうした状態が続くと、
見えないところでカビが根を張っている可能性があります。
✅ チェック③ 黒ずみ・シミが繰り返し出てくる
掃除しても、
・同じ場所に黒ずみが出る
・時間がたつとまたシミが浮いてくる
これは、表面ではなく内部に原因が残っているサインです。
「また出た…」
と感じた時点で、再発型のカビトラブルを疑ったほうが安心です😣
✅ チェック④ 体調の変化が室内で起きやすい
次のようなことはありませんか?
✔ 家にいると咳や鼻の違和感が出る
✔ 朝起きると喉がイガイガする
✔ 外に出ると楽になる
これらは必ずしもカビが原因とは限りませんが、
室内環境が影響している可能性は考えられます。
✅ チェック⑤ 家電・水回りの汚れが気になる
・加湿器の内部
・食洗機の奥
・排水口のぬめり
「掃除しているのに、なんだか黒っぽい…」
と感じたら、黒色真菌などのカビが関係している可能性もあります。
🤔 ひとつでも当てはまったら…
これらのチェック項目に
ひとつでも当てはまる場合、
「今すぐ大問題!」というわけではありません😊
ですが、
👉 一度きちんと確認しておく
👉 現状を知っておく
ことで、
・不要な不安を減らす
・将来の大きなトラブルを防ぐ
ことにつながります✨
🌱 早めの確認が、いちばん安心
カビ問題は、
「ひどくなってから」より
**「気になり始めたとき」**の対応がとても大切です。
「これって相談するほどかな…?」
と迷う段階こそ、一番ちょうどいいタイミングかもしれません😊
次の章では、
👉 東北地方のカビ問題をどう解決しているのか
👉 カビバスターズ仙台が大切にしている考え方
をお伝えしていきます🌸
東北地方のカビ問題はお任せください|カビバスターズ仙台が大切にしていること
「どこに相談すればいいかわからない…」そんな時こそ、地域密着の専門相談を
カビの問題は、
「どこに相談すればいいのか分からない」
「これくらいで相談してもいいのかな…?」
と、最初の一歩を迷われる方がとても多いお悩みです😌
特に、
・原因がはっきりしない
・何度も再発している
・見えない場所が気になる
といったケースほど、ひとりで悩み続けてしまいがちです。
🏠 東北の住まいには、東北ならではのカビ事情がある
東北地方は、
✔ 寒暖差が大きい
✔ 冬場の結露が起きやすい
✔ 気密性の高い住宅が多い
といった特徴があり、カビが発生しやすい条件がそろいやすい地域でもあります。
「うちだけがおかしいのかな?」
と感じてしまう方もいらっしゃいますが、
決して珍しいことではありません😊
🌱 私たちが大切にしているのは「原因を知ること」
カビバスターズ仙台では、
✔ なぜカビが出たのか
✔ どこに原因があるのか
✔ 再発の可能性はどのくらいか
といった点を、ひとつひとつ丁寧に考えることを大切にしています。
目に見えるカビだけを見るのではなく、
住まい全体の状態を理解することが、安心への近道だからです。
🔍 不安なまま暮らさないために
「今すぐどうこうしたいわけじゃないけど…」
「まずは話を聞いてほしい」
そんなご相談も、もちろん大丈夫です😊
カビの問題は、
放置すればするほど分かりにくくなり、不安が大きくなることがあります。
だからこそ、
👉 早めに現状を知る
👉 判断材料を持つ
ことが、とても大切です。
🤝 手に負えないと感じたら、無理をしないでください
市販の洗剤やご自身での掃除で、
「もう限界かも…」
と感じたら、それは相談すべきサインです⚠️
無理に一人で抱え込まず、
専門的な視点で一度確認してみることで、
気持ちがぐっと楽になる方もたくさんいらっしゃいます🌸
🌼 東北の住まいと健康を守るために
カビバスターズ仙台は、
東北地方の住環境と、そこに暮らす方の安心を大切にしています。
・原因をきちんと知りたい
・再発しないか不安
・家族の健康が心配
そんなお気持ちが少しでもあれば、
「こんなことで相談していいのかな?」と思わずに、
お気軽にご相談ください😊
自分で対処が難しいと感じたら…早めの相談が安心への近道
悩み続けるより、まずは話してみませんか?カビ問題は“ひとりで抱えない”ことが大切です
ここまでお読みいただき、ありがとうございます😊
Exophiala(エクソフィアラ)という黒色真菌について、
「もしかして、うちも当てはまるかも…」
と感じた方もいらっしゃるのではないでしょうか。
カビの問題は、
👉 目に見えにくい
👉 正解が分かりにくい
👉 誰に相談すればいいか迷う
という特徴があり、知らないうちに不安だけが大きくなってしまうことがあります😥
🤔 無理に自分で解決しようとしなくて大丈夫
「もう少し様子を見よう」
「自分で何とかできるかも」
そう思って試行錯誤される方はとても多いです。
ですが、
✔ 何度も同じ場所にカビが出る
✔ 見えない場所が気になる
✔ 原因が分からず不安が続く
こうした状態になっているなら、
**それは“自分で抱えなくていいサイン”**かもしれません🍀
🌱 早めに相談するメリット
カビ問題は、
ひどくなってから対応するより、早めに確認する方が負担が少ない
という特徴があります。
早めに相談することで、
✔ 本当に問題があるのか分かる
✔ 今すぐ対応が必要か判断できる
✔ 不要な心配を手放せる
といった安心につながる情報を得ることができます😊
🔍 「何もなければ、それも安心」
相談や調査の結果、
「特に大きな問題はありませんでした」
というケースも、決して少なくありません✨
それは、
👉 これからも安心して暮らせる
👉 無駄な不安を抱えなくていい
という、とても大切な結果です。
🌼 東北のカビトラブルは、地域を知る相談先へ
東北地方の住まいは、
寒暖差・結露・高気密住宅など、地域特有のカビリスクがあります。
だからこそ、
東北の環境を理解した相談先に話すことで、
「うちの場合はどうなのか?」
が、より分かりやすくなります😊
📩 最後に|ひとりで悩まず、気軽にご相談ください
カビの悩みは、
決して珍しいことではありません。
そして、相談することは特別なことでもありません。
・少し話を聞いてほしい
・不安を整理したい
・今の状態を知りたい
そんな気持ちがあれば、それで十分です🌸
手に負えないと感じたカビトラブルは、
MIST工法®カビバスターズ仙台へ。
東北の住まいと、そこに暮らす皆さまの安心のために、
私たちはいつでもご相談をお待ちしています😊✨
----------------------------------------------------------------------
カビバスターズ仙台
MPソリューション株式会社
〒980-0013
宮城県仙台市青葉区花京院2-1-61
オークツリー仙台1F
電話番号 022-208-8966
つながらない場合 直通090-8957-8975
----------------------------------------------------------------------